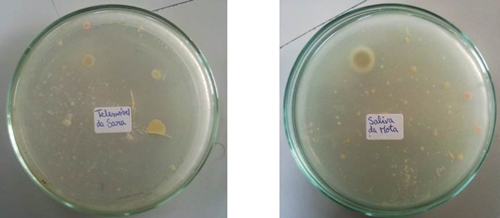
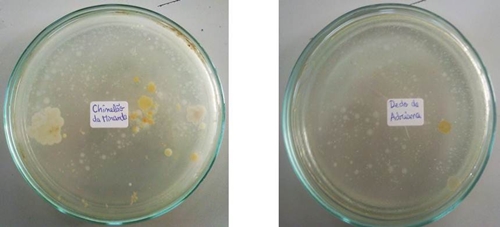
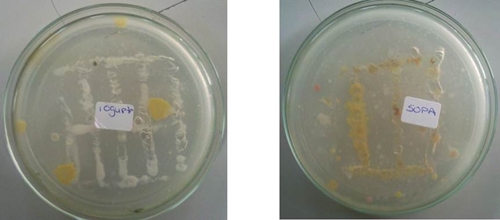
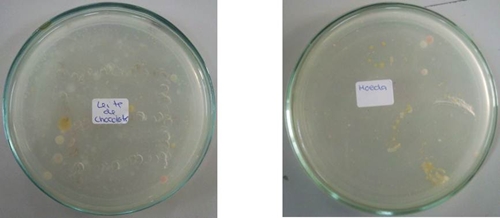

|
RELATÓRIO DO TRABALHO LABORATORIATema: Como pode testar-se a presença de bactérias em objectos que utilizamos frequentemente? Capítulo I: Introdução A actividade laboratorial tem como objectivo testar a presença de bactérias em objectos que utilizamos no nosso quotidiano. As bactérias são os seres vivos mais elementares a nível estrutural (unicelulares) e de menor tamanho. São procariontes, uma vez que não possuem membrana nuclear, estando o seu material genético (DNA na forma de molécula circular) concentrado numa região denominada nucleóide. Muitas bactérias têm também pequenos anéis de DNA (plasmídeos) que contêm genes acessórios. Apesar de não possuírem organelos como mitocôndrias, plastos, retículo e complexo de Golgi, possuem ribossomas e todas as estruturas necessárias à realização de biossínteses e transformações energéticas, de maneira a garantirem a sua autonomia quanto à reprodução e obtenção de energia. Existem inúmeras espécies de bactérias e em grande abundância em nosso redor, sendo algumas benéficas ao ser humano e outras, pelo contrário, causadoras de doenças (patogénicas) que podem comprometer a vida deste. É de salientar a importância da cultura de bactérias, especialmente para proveito do ser humano (como é o caso da cultura da bactéria E. coli modificada para a produção de insulina). Nesta actividade laboratorial, vai realizar-se a cultura de bactérias, ou seja, promover o crescimento de colónias destes seres vivos de forma induzida pelo Homem para facilitar o seu estudo. Para isso é necessário inocular (introduzir artificialmente microorganismos num meio específico), com um objecto de uso corrente, um meio de cultura (substância que permitirá a nutrição, crescimento e a multiplicação dos microorganismos). Para além disso, procedeu-se ainda à inoculação do meio de cultura com alguns alimentos. Capítulo II: Resultados
* apesar de se tratar do controlo, foram observadas algumas colónias de bactérias
Fig. 1 – Caixa de Petri nº 1 Fig. 2 – Caixa de Petri nº 2 (inoculação com telémovel) (inoculação com saliva)
Fig. 3 – Caixa de Petri nº 3 Fig. 4 – Caixa de Petri nº 4 (inoculação com porta-chaves) (inoculação com dedo)
Fig. 5 – Caixa de Petri nº 5 Fig. 6 – Caixa de Petri nº 6 (inoculação com iogurte) (inoculação com sopa)
Fig. 7 – Caixa de Petri nº 7 Fig. 8 – Caixa de Petri nº 8 (inoculação com leite chocolatado) (inoculação com moeda)
Fig. 9 – Caixa de Petri nº 9 (controlo - sem inoculação)
Capítulo III: Discussão e Conclusão Após a realização desta actividade laboratorial confirmou-se que, realmente, as bactérias estão presentes em tudo o que nos rodeia. De acordo com os resultados obtidos, verifica-se que todos os objectos e alimentos utilizados na inoculação do meio de cultura possuíam colónias de bactérias. Estas colónias, apesar de serem grupos de indivíduos de dimensões extremamente reduzidas, são claramente visíveis a olho nu, uma vez que são constituídas por um grande número de bactérias. É ainda de realçar que, em boas condições ambientais (como é o caso da actividade realizada, uma vez que foi fornecido um meio de cultura), estes seres vivos reproduzem-se muito rapidamente, podendo ocorrer uma divisão em cada 20-25 minutos. Foi possível observar colónias que possuíam cores variadas (principalmente tons amarelos, laranjas e esverdeados), pelo qual se conclui que se tratavam de espécies de bactérias diferentes. A existência de fungos em algumas caixas de Petri deve-se ao facto de este grupo de seres vivos existir em grande quantidade e contaminarem facilmente um meio de cultura como aquele em que foi realizada a actividade experimental (graças aos seus esporos). Normalmente, quando são realizadas inoculações, utiliza-se um anti-fúngico para impedir o aparecimento destes fungos, mas como a nossa cultura é de tamanho reduzido não se justificava fazer este tipo de tratamento. A caixa de Petri nº 9 serviu como controlo dos resultados da actividade, uma vez que não se procedeu à inoculação do meio de cultura presente nesta caixa. No entanto, foi possível observar algumas colónias de bactérias no controlo, o que não é de admirar, uma vez que, para se tratar de um controlo realizado nas condições ideais, deveria ser executado num meio esterilizado de maneira a não ser contaminado pelas bactérias do meio envolvente ou até pela pessoa que procedeu à preparação do meio de cultura desta caixa de Petri. Por outro lado, para resultados mais correctos, todo o processo de inoculação deveria ter sido realizado numa câmara esterilizada para evitar a contaminação do meio de cultura com bactérias, o que não foi possível na nossa actividade prática. Poderíamos chegar ainda um pouco mais longe nesta actividade, tentando identificar as diferentes espécies de bactérias presentes. Para isso seria necessário fazer uma nova inoculação com bactérias retiradas das colónias da primeira inoculação, tentando garantir, assim, a presença apenas de indivíduos da mesma espécie para posteriormente serem analisados. Sumário: Esta actividade laboratorial permite-nos testar a presença de bactérias em objectos que usamos no nosso dia-a-dia e observar a reprodução destes seres vivos quando em condições ambientais favoráveis. Podemos, portanto, afirmar a quase omnipresença das bactérias. Concluiu-se que se pode facilmente proceder ao cultivo de bactérias, através da inoculação de um meio de cultura, e que este processo têm algumas vantagens importantes para o ser humano. Bibliografia: LEAL, Júlia Isabel; Técnicas Laboratoriais de Biologia, 1ª edição, Edições Asa, 1994 SILVA, Amparo Dias da; Terra, Universo de Vida - 12º ano, 1ª edição, Porto Editora, 2011 http://www.notapositiva.com/trab_estudantes/trab_estudantes/biologia/biologia_ trabalhos/culturabacterias.htm – Cultura de Bactérias, cons. 20/01/2012 http://pt.wikipedia.org/wiki/Bact%C3%A9ria - Bactéria (Wikipédia), cons. 20/01/2012
Outros Trabalhos Relacionados
|
|